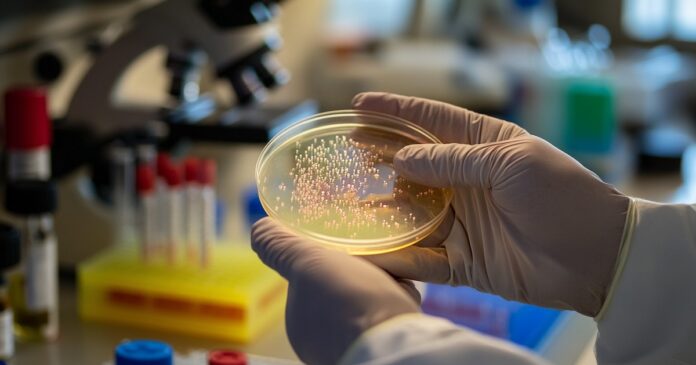

La “pandrogo-resistencia” es la resistencia de un patógeno que afecta la salud humana o animal a todos los medicamentos antimicrobianos, como los antibióticos. Es decir, son superbacterias que pueden sobrevivir a la acción de medicamentos disponibles.
En Argentina, investigadores del Servicio de Antimicrobianos del Instituto ANLIS-Malbrán descubrieron que los casos de resistencia, especialmente en bacterias como Klebsiella pneumoniae, Pseudomonas aeruginosa, y el complejo Acinetobacter baumannii, crecieron de manera preocupante.
Los hallazgos fueron informados en el último Boletín Epidemiológico del Ministerio de Salud de la Nación.
“Las infecciones causadas por bacterias multirresistentes representan una amenaza creciente para la salud pública, especialmente en pacientes internados en unidades de cuidados críticos”, advirtieron en el boletín.
En 2023, se reportaron pacientes con infecciones por Klebsiella resistentes a todos los fármacos conocidos. NIAID
En enero de 2023, ya se habían detectado casos de pacientes con la bacteria Klebsiella pneumoniae que fueron resistentes a todos los fármacos disponibles. Eso ocurrió en instituciones hospitalarias de la ciudad de Buenos Aires.
A partir de entonces, se crearon mecanismos para que se notifiquen las detecciones de microorganismos con perfil de pan-resistencia al Sistema Nacional de Vigilancia de la Salud.
El aumento sostenido de microorganismos resistentes pone en riesgo la eficacia de los tratamientos disponibles y puede originar brotes hospitalarios de difícil contención.
¿Qué se sabe sobre las superbacterias en Argentina?
De acuerdo con los reportes realizados entre 2020 y 2024, los patógenos involucrados en la “pandrogo-resistencia” en la Argentina abarcan los siguientes tres microorganismos:
Klebsiella pneumoniae
Klebsiella pneumoniae alcanza más del 50% de resistencia en múltiples antimicrobianos en Argentina/Archivo
Es la bacteria de mayor preocupación. Presenta una alta prevalencia en infecciones urinarias, hemocultivos y muestras respiratorias.
Se han detectado niveles superiores al 50% en resistencia a múltiples antimicrobianos. Hubo un incremento en la resistencia de Klebsiella a los fármacos carbapenemes (30,8% en 2022 a 32,2% en 2023).
Recientemente, se conoció que ese patógeno fue encontrado en 18 pacientes en un hospital de La Plata, provincia de Buenos Aires, de los cuales 9 fallecieron. La autoridad regulatoria nacional de medicamentos, la ANMAT, realizó una denuncia penal tras vincular esos casos con una partida contaminada de fentanilo de uso medicinal, tal como contó Infobae.
Pseudomonas aeruginosa
Pseudomonas aeruginosa presenta resistencia del 39% en infecciones respiratorias, y 22% en urinarias. (CSIC)
La bacteria Pseudomona aeruginosa puede causar infecciones en la sangre, los pulmones (como la neumonía), el tracto urinario u otras partes del cuerpo después de la cirugía.
Se propaga a través del contacto con superficies o equipos contaminados o por el contacto de persona a persona, como por ejemplo a través de manos.
Los investigadores encontraron que la resistencia detectada en infecciones respiratorias llega al 39% y al 22% en urinarias. Señalaron que hubo un incremento notable de aislados con la enzima carbapenemasas del tipo NDM, que confiere resistencia a los patógenos.
Acinetobacter baumannii
Acinetobacter baumannii, con el mecanismo OXA-23, dificulta tratar infecciones respiratorias Centers for Disease Control
Esta bacteria puede causar infecciones en la sangre, las vías urinarias, los pulmones (neumonía) o heridas, y puede propagarse en entornos de atención médica a través del contacto con superficies o equipos contaminados.
También por el contacto con otras personas con la infección. En algunos casos, las personas pueden ser portadoras de la bacteria sin estar infectadas, lo que se conoce como colonización.
En el Boletín, los investigadores argentinos contaron que estudiaron 8.828 aislamientos clínicos con la bacteria acinetobacter baumannii. La mitad de ellos era casos por infecciones respiratorias.
Detallaron que OXA-23 es el principal mecanismo de resistencia de la bacteria en el país, con casos emergentes de NDM.
La prevención frente a las superbacterias
El sistema nacional implementó mecanismos para notificar detecciones de microorganismos con pan-resistencia (Imagen Ilustrativa Infobae)
Los investigadores del Malbrán recomendaron aplicar de inmediato precauciones de contacto para pacientes con sospecha de tener superbacterias en los hospitales. Se deben atender en habitaciones individuales y limitar los traslados para estudios. De esta manera se reduce el riesgo de propagación.
También se deberían aumentar la frecuencia e intensidad de las prácticas de higiene hospitalaria y la desinfección ambiental y capacitar al personal de salud.
En diálogo con Infobae, el médico infectólogo Pablo Scapellato, profesor de la Universidad Fundación Favaloro y presidente del comité organizador del congreso 2025 de la Sociedad Argentina de Infectología (SADI), comentó tras leer el Boletín de la cartera de Salud nacional: “La situación de la pandro-resistencia me parece preocupante. Nos pone ante la situación de quedarnos sin herramientas para tratar infecciones que pueden ser muy graves”.
El mal uso de antibióticos y prácticas comunitarias inadecuadas agravan el problema de resistencia bacteriana. (Imagen Ilustrativa Infobae)
El problema “es fundamentalmente intrahospitalario. Allí hay que trabajar más con medidas de prevención y control de las infecciones asociadas al cuidado de la salud y mejorar el uso de antibióticos”, dijo.
En tanto, Francisco Nacinovich, jefe de infectología del Instituto Cardiovascular (ICBA), miembro de SADI y cofundador de la asociación civil sin fines de lucro INVERA, subrayó que la “pandrogo-resistencia es un gran desafío porque nos deja sin fármacos útiles para tratar a los pacientes. Es la punta del iceberg de un grave problema de salud pública”.
“La Argentina es uno de los países con mayores niveles de resistencia en bacilos Gram negativos en el mundo. Pero hay muchas acciones que todos podemos hacer, como el lavado de mano frecuente, no compartir antibióticos con amigos o vecinos, y usar los medicamentos en el tiempo prescripto”, añadió.
(Imagen Ilustrativa Infobae)
No se deben descartar los medicamentos en el inodoro o en el lavatorio porque contaminan el ambiente. Nacinovich también mencionó que ahora “hay más test de diagnóstico para evitar indicar antibióticos cuando no se los necesita y tratamientos acotados”.
Tanto la población general como los profesionales de la salud pueden ser parte de la solución al grave problema. “En Argentina, se debería impulsar una plena implementación de la ley nacional para el uso responsable de los antibióticos”, sostuvo el experto.